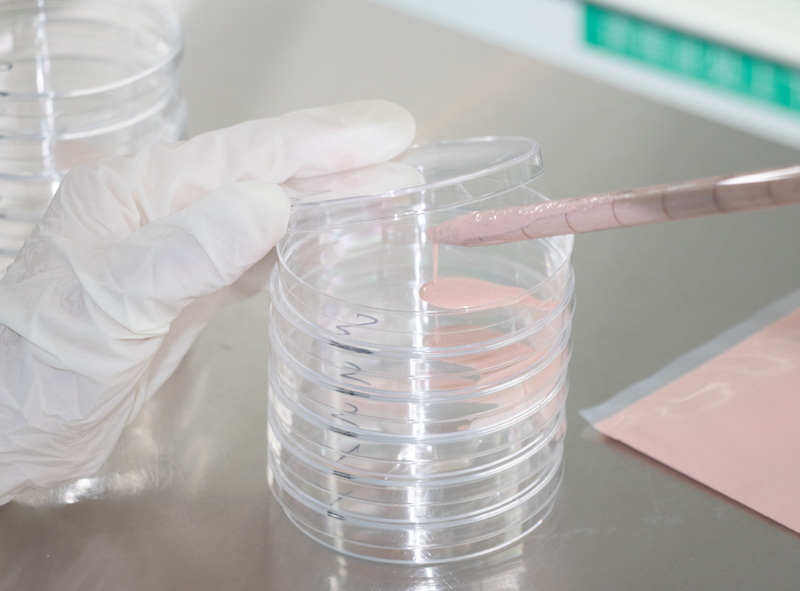

At Diefei, we take immense pride in our role as a comprehensive one-stop solution provider in the cosmetic industry. Since our establishment in 1996, we have evolved into an internationally renowned cosmetics OEM/ODM company. Our factory spans 190,000 square meters across two production bases, manufacturing a full range of products from facial, lip, and eye cosmetics to skincare and baby care product categories.
We operate under GMPC, ISO9001, ISO14001, and BRC systems, ensuring all our processes comply with local and international regulations. The entire production process, from the contract with supplier, incoming raw materials, production, testing, packaging and labeling to delivery is under meticulous quality control. We seamlessly blend quality, efficiency, and exceptional customer service to elevate your brand!
Excellence is the hallmark of our cosmetic manufacturing prowess. Annual production boasts an impressive 400 million pressed powder granules, 60 million lipsticks, and 110 million packaging boxes. With a daily capacity of 2,000,000 units, our commitment to manufacturing excellence speaks volumes. Spread across our expansive production facility, our cutting-edge production lines are equipped with state-of-the-art automated machines. From an automatic silicone mold lipstick line to a fully-automatic monochrome (multi-color) powder press and powder assembly line, we’ve embraced innovation at every step.
















Quality is at the core of our products, and we achieve it through strategic alliances with industry giants like Sun Chemical, Merck Chemical, Karl Germany, BASF, Dow Chemical, and more. Recognizing that exceptional products begin with top-notch raw ingredients, we’ve woven a web of partnerships that form the foundation of our quality commitment.

Various tests are conducted during the production process to ensure quality throughout.
Regulatory authorities’ compliance, legal requirements and industry standards in the market where the products will be sold are examined. This allows us to verify and comply with the market’s legal requirements and safety guidelines.
Raw materials, including pigments and fragrances, are assessed to ensure they meet specified quality standards before being incorporated into the cosmetic formulation. This includes testing for tests for purity, stability, and compatibility. Heavy metal testing (a massive concern in the beauty industry) is conducted using a specialized Plasma Mass Spectrometer.
To maintain consistent quality throughout the production and identify any deviations, multiple tests are conducted during the production, during mixing, filling, and packaging etc. Factors like product texture, color and fragrance and product stability are tested to ensure conformity.
A trial product is manufactured and tested before the launch to identify potential challenges before full-scale production. This small-scale production run mirrors the mass production process, allowing us to evaluate the entire production cycle, from ingredient mixing to packaging. By conducting trials, we can proactively address issues, reduce the likelihood of defects, and maintain our reputation for high-quality cosmetic products.
Our production covers a broad spectrum of testing projects, including finished products, semi-finished products, raw materials, and various organic, inorganic, and microbial testing. This demonstrates our dedication to ensuring the quality of our products and to remain on the list of the top beauty manufacturing companies in the world.
Ready to elevate your brand with high-quality, customized cosmetics? Partner with Diefei today and let us bring your vision to life. Contact us now to get started!
Address: No. 21, Jing’er Road, Beiyuan, Yiwu City, Zhejiang Province, China
Tel: 86-579-85421988 86-579-85421989
WhatsApp: +8615957923862
Email: sales@diefei.com